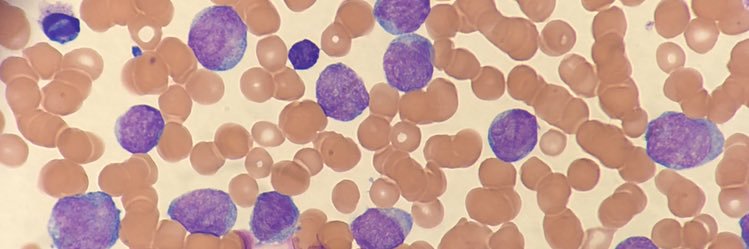
Heather J. Male, MD, MBA banner

Heather J. Male, MD, MBA retweetet

This is @BartScott8 signing off. We had a great day on Capitol Hill advocating for NIH research and sickle cell comprensive care act as we #Fight4Hematology. It was great seeing my dear friends on the government affairs committee @LeukemiaMD

English